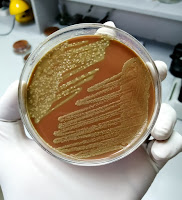

MOMENTO SAÚDE E BEM-ESTAR: Meningite: vacinação e diagnóstico correto são aliados da prevenção
MOMENTO SAÚDE E BEM-ESTAR: Meningite: vacinação e diagnóstico correto são aliados da prevenção
Dia 24 de Abril é o Dia Mundial de Combate à Meningite. Segundo o Ministério da Saúde, no Brasil, entre os anos de 2007 e 2020, foram notificados 393.941 casos suspeitos de meningite. Destes, foram confirmados 265.644, sendo a meningite viral a mais frequente, seguida pela bacteriana. A meningite é um processo inflamatório das meninges, membranas que envolvem o cérebro e a medula espinhal.
De acordo com a Fiocruz, no país, a meningite é considerada uma doença endêmica, ou seja, casos do problema são esperados ao longo de todo o ano, sendo mais comum a ocorrência das meningites bacterianas no inverno e das virais, no verão. Com a chegada do frio, os ambientes tendem a ficar fechados e mal ventilados, facilitando a transmissão. Por isso, além das medidas gerais de higiene, como lavar as mãos, não compartilhar talheres e alimentos, manter ambiente e brinquedos higienizados, é importante também a vacinação.
Outro fator importante para interromper a cadeia de transmissão e evitar mortes pela doença é o diagnóstico correto. Vale ressaltar que a meningite mata uma em cada 10 pessoas infectadas - principalmente crianças e jovens - e deixa uma em cinco com incapacidades de longa duração, como convulsões, perda de audição e visão, danos neurológicos e deficiência cognitiva.
Com sede em São José dos Pinhais (PR), a Firstlab desenvolve e fabrica produtos e equipamentos para Laboratórios de Análises Clínicas, inclusive para o diagnóstico da meningite, como Câmara de Fuchs-Rosenthal, microscópio, centrífuga, placas de petri, meios de cultura, micropipetas e muito mais.
Viviane Ceschim, assessora científica da Firstlab, explica que o diagnóstico laboratorial é importante para confirmar ou não a suspeita clínica, sendo que o padrão-ouro é a cultura de líquor e análise bioquímica do líquor. “Além do líquor (amostra principal), outras amostras biológicas podem ser utilizadas para diagnosticar a meningite, como sangue ou raspado de petéquias (lesões avermelhadas na pele) no caso de meningite bacteriana, e sangue ou fezes no caso da meningite viral. Costuma-se solicitar, ainda, exames de sangue e urina para avaliar o estado geral do paciente”, afirma.
Sobre a FirstLab - A FirstLab faz parte de um grupo sólido de empresas que trabalha pela vida, com mais de 25 anos de atuação e grande conhecimento no mercado da saúde. Desenvolve e fabrica produtos e equipamentos para Laboratórios de Análises Clínicas, promovendo segurança, inovação e tecnologia nas rotinas laboratoriais sempre pensando na sustentabilidade e atuando com responsabilidade. Aceda a www.firstlab.ind.br
Comentários